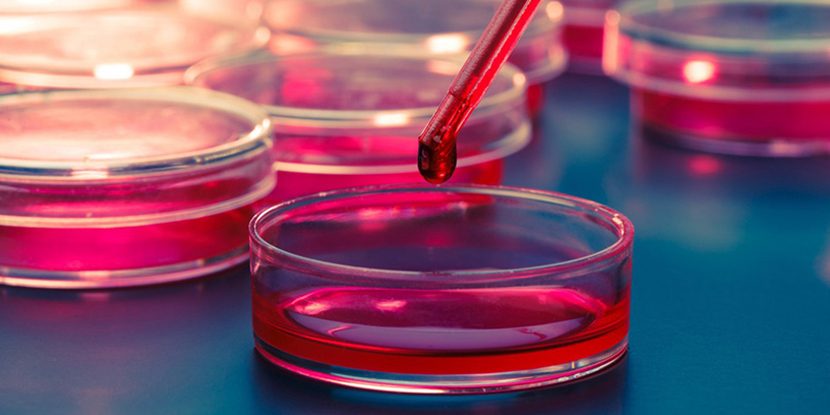
Sertleşme Sorununda Kök Hücre Tedavisi

iktidarsızlık
İktidarsızlık, Erektil Disfonksiyon, Sertleşme Sorunu
İktidarsızlık, Erektil Disfonksiyon, Sertleşme Sorunu Tedavisi
Erkeklerin en çok karşılaştığı problemlerden olan iktidarsızlık sorununa kliniğimizde kişiye özel ve modern tedavilerle kalıcı çözüm…
Erektil disfonksiyon, iktidarsızlık, impotans ifadeleriyle tanımlanan sertleşme sorunu 3 ay veya daha uzun süreden beri sürekli veya tekrarlayan biçimde, penisin cinsel birleşme için gerekli sertliğe ulaşmaması veya oluşan sertliği koruyamamasıdır.
Sertleşme sorunu altında yatan nedenlerin araştırılması için uzman hekim desteği şarttır. Aksi halde sertleşme sorunu varlığında internet ortamında veya arkadaş tavsiyesi ile belirlenen bir tedaviye karar verilip uygulanmamalıdır.
Dünya Sağlık Örgütü verilerine göre; Türkiye’de 40 yaşın üzerindeki erkeklerde sertleşme sorunu %69 oranında belirlenmiştir. Dünya genelinde 20-75 yaş aralığındaki tüm erkeklerin %16’sında bulunmaktadır.

Sertleşme Sorunu İçin Risk Grubunda Mısınız?
Tedavi Yöntemleri
Erektil disfonksiyon için Türkiye’de ilk defa 2015 yılında kalıcı tedavi yöntemleri (ozonlu PRP, P shot, 2. jenerasyon şok dalga tedavisi (lineer şok dalga tedavisi, LSWT-Renova) ve kök hücre tedavisi) kliniğimizde uygulanmaya başlamıştır. Bu konuda en başarılı klinik olmamızın sırrı da “hastaya özel kişiselleştirilmiş tedavi yöntemini” uygulamaktır. Daha açık söylemek gerekirse, sertleşme sorunu her hastada farklı nedenlerle ortaya çıkmaktadır. Aynı nedenlerle ortaya çıksa bile, etkilenme düzeyi farklı olmaktadır. Dolayısıyla, tedavi yöntemlerinden her hastanın aynı şekilde fayda görmesini bekleyemeyiz. Bu nedenle her hasta detaylıca değerlendirilmeli, fayda görmesi en uygun tedavi yöntemi belirlenmeli ve uygulanmalıdır. Aksi halde, zararlı olabilecek veya sonuç elde edilemeyecek yöntem uygulayarak gereksiz vakit ve ücret kaybı yaşanabilir.



Prof. Dr. Sinan Ekici İle Daha Sağlıklı Bir Hayat!
Modern tedavi yöntemleri, tedavi öncesi ve sonrası profesyonel destek, mutlu ve sağlıklı bir hayat! Uluslararası uygulamalar, bilimsel tedavi yaklaşımları, 25 yıllık deneyim ve hasta memnuniyetiyle Türkiye’nin en iyi üroloji kliniği!
İlk Randevu
Hastalarla ilk randevu ve muayenenin planlanması, şikayetlerinin dinlenmesi üzerine gerçekleştirilir.
Teşhis
Gelişmiş tanı yöntemlerinin kullanılarak, tedaviden önce hastalığın en doğru tanımı yapılmaktadır.
Tedavi Planı Oluşturma
Hastanın genel sağlık durumuna, yaşına ve diğer etmenlere göre tedavi şeklinin oluşturulması.

Tedavi Uygulama
Dünya standartlarına uygun, en yeni ve modern yöntemlerle kişiye özel tedavi uygulamaları.
Tedavi Sonrası Kontroller
Her hasta için özel olarak düzenli kontrollerinin yapılması, sağlık durumunun incelenmesi.
Koruyucu Uygulamalar
Tedavi sonrasında yaşam şeklinin değiştirilmesi, psikolojik destek ve koruyucu önlemler alınması.
Sorularınız mı var? Hemen bizi arayın!
İktidarsızlık, Erektil disfonksiyon, Sertleşme Sorunu Nedir? – Hastalığınızı Yakından Tanıyın!
Sertleşme sorununun psikolojik ve organik nedenleri hakkında bilgi sahibi olmak ister misiniz? Erektil disfonksiyon altında yatan nedenlerin belirlenmesi ve karşı önlem alınması bu sorunun çözülmesinde katkı sağlayacaktır. Bu süreçte de uzman desteğimizden yararlanabilirsiniz.
Sertleşme Sorunu Tedavisi Sonrası Dikkat Edilmesi Gerekenler
Sertleşme sorunu tedavisi sonrasında, soruna neden olan faktörlerden uzak durmak ve kontrolleri aksatmamak gerekmektedir.
Sigara içmemek, aşırı alkol tüketmemek, sağlıklı ve dengeli beslenmek, egzersiz yapmak dikkat edilmesi gereken durumlardır. Sertleşme sorunu tedavisi sonrasında düzelen cinsel yaşamınızın sağlıklı bir şekilde devam etmesi için, yaşam alışkanlıklarınızı değiştirmenizi, olası problemlerde vakit kaybetmeden kliniğimize ulaşmanızı öneririz.